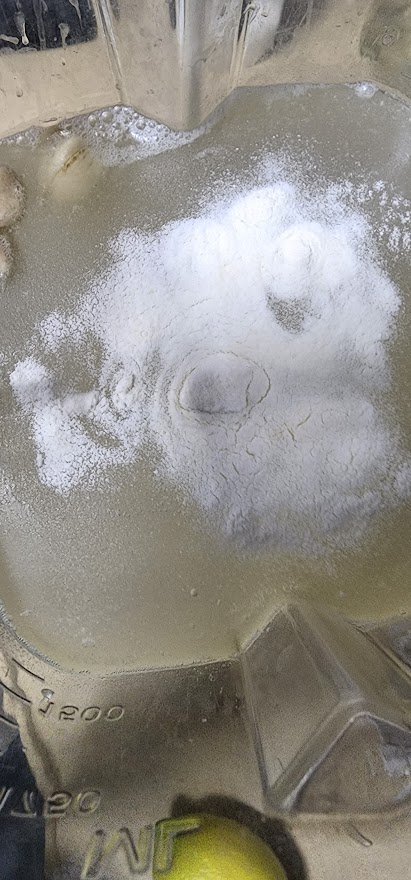

- המתכון
- ערכים תזונתיים
שמנת חמוצה טבעונית שכולם מדברים עליה
שמנת חמוצה פרוביוטית, על אמת! מתכון מדוייק שיפיל אתכם! היא קרמית, חמוצה, בריאה, מזינה עם המרקם הזה שנשבר שמזכיר את הילדות- הצגה!
אופן הכנת השמנת החמוצה
לסנן את הקשיו ולהעביר לבלנדר חזק במיוחד.
לבלנדר במשך 3-4 דקות על מנת שהטמפרטורה של המסה תעלה בעקבות הסחרור של הבלנדר.
להמשיך לבלנדר לעוד 4-5 דקות.
לטעום שטעים ומאוזן.
אתם הולכים להתמכר
בתיאבון!